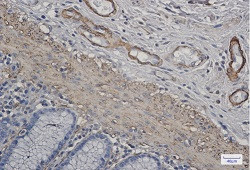
ACTA1 Antibody in Immunohistochemistry (Paraffin) (IHC (P))

Search
Abnova
ACTA1 Recombinant Rabbit Monoclonal Antibody
{{$productOrderCtrl.translations['antibody.pdp.commerceCard.promotion.promotions']}}
{{$productOrderCtrl.translations['antibody.pdp.commerceCard.promotion.viewpromo']}}
{{$productOrderCtrl.translations['antibody.pdp.commerceCard.promotion.promocode']}}: {{promo.promoCode}} {{promo.promoTitle}} {{promo.promoDescription}}. {{$productOrderCtrl.translations['antibody.pdp.commerceCard.promotion.learnmore']}}
图: 1 / 2
ACTA1 Antibody (RAB02088) in IHC (P)


产品信息
RAB02088
种属反应
宿主/亚型
Expression System
分类
类型
抗原
偶联物
形式
纯化类型
保存液
内含物
保存条件
运输条件
靶标信息
The product encoded by this gene belongs to the actin family of proteins, which are highly conserved proteins that play a role in cell motility, structure and integrity. Alpha, beta and gamma actin isoforms have been identified, with alpha actins being a major constituent of the contractile apparatus, while beta and gamma actins are involved in the regulation of cell motility. This actin is an alpha actin that is found in skeletal muscle. Mutations in this gene cause nemaline myopathy type 3, congenital myopathy with excess of thin myofilaments, congenital myopathy with cores, and congenital myopathy with fiber-type disproportion, diseases that lead to muscle fiber defects.
仅用于科研。不用于诊断过程。未经明确授权不得转售。
篇参考文献 (0)
生物信息学
蛋白别名: ACTA1; actin alpha 1; Actin, alpha skeletal muscle; alpha-actin; Alpha-actin-1; nemaline myopathy type 3; unnamed protein product
基因别名: ACTA; ACTA1; ASMA; CFTD; CFTD1; CFTDM; CMYO2A; CMYO2B; CMYO2C; CMYP2A; CMYP2B; CMYP2C; MPFD; NEM1; NEM2; NEM3; SHPM
UniProt ID: (Human) P68133, (Rat) P68136
Entrez Gene ID: (Human) 58, (Rat) 29437